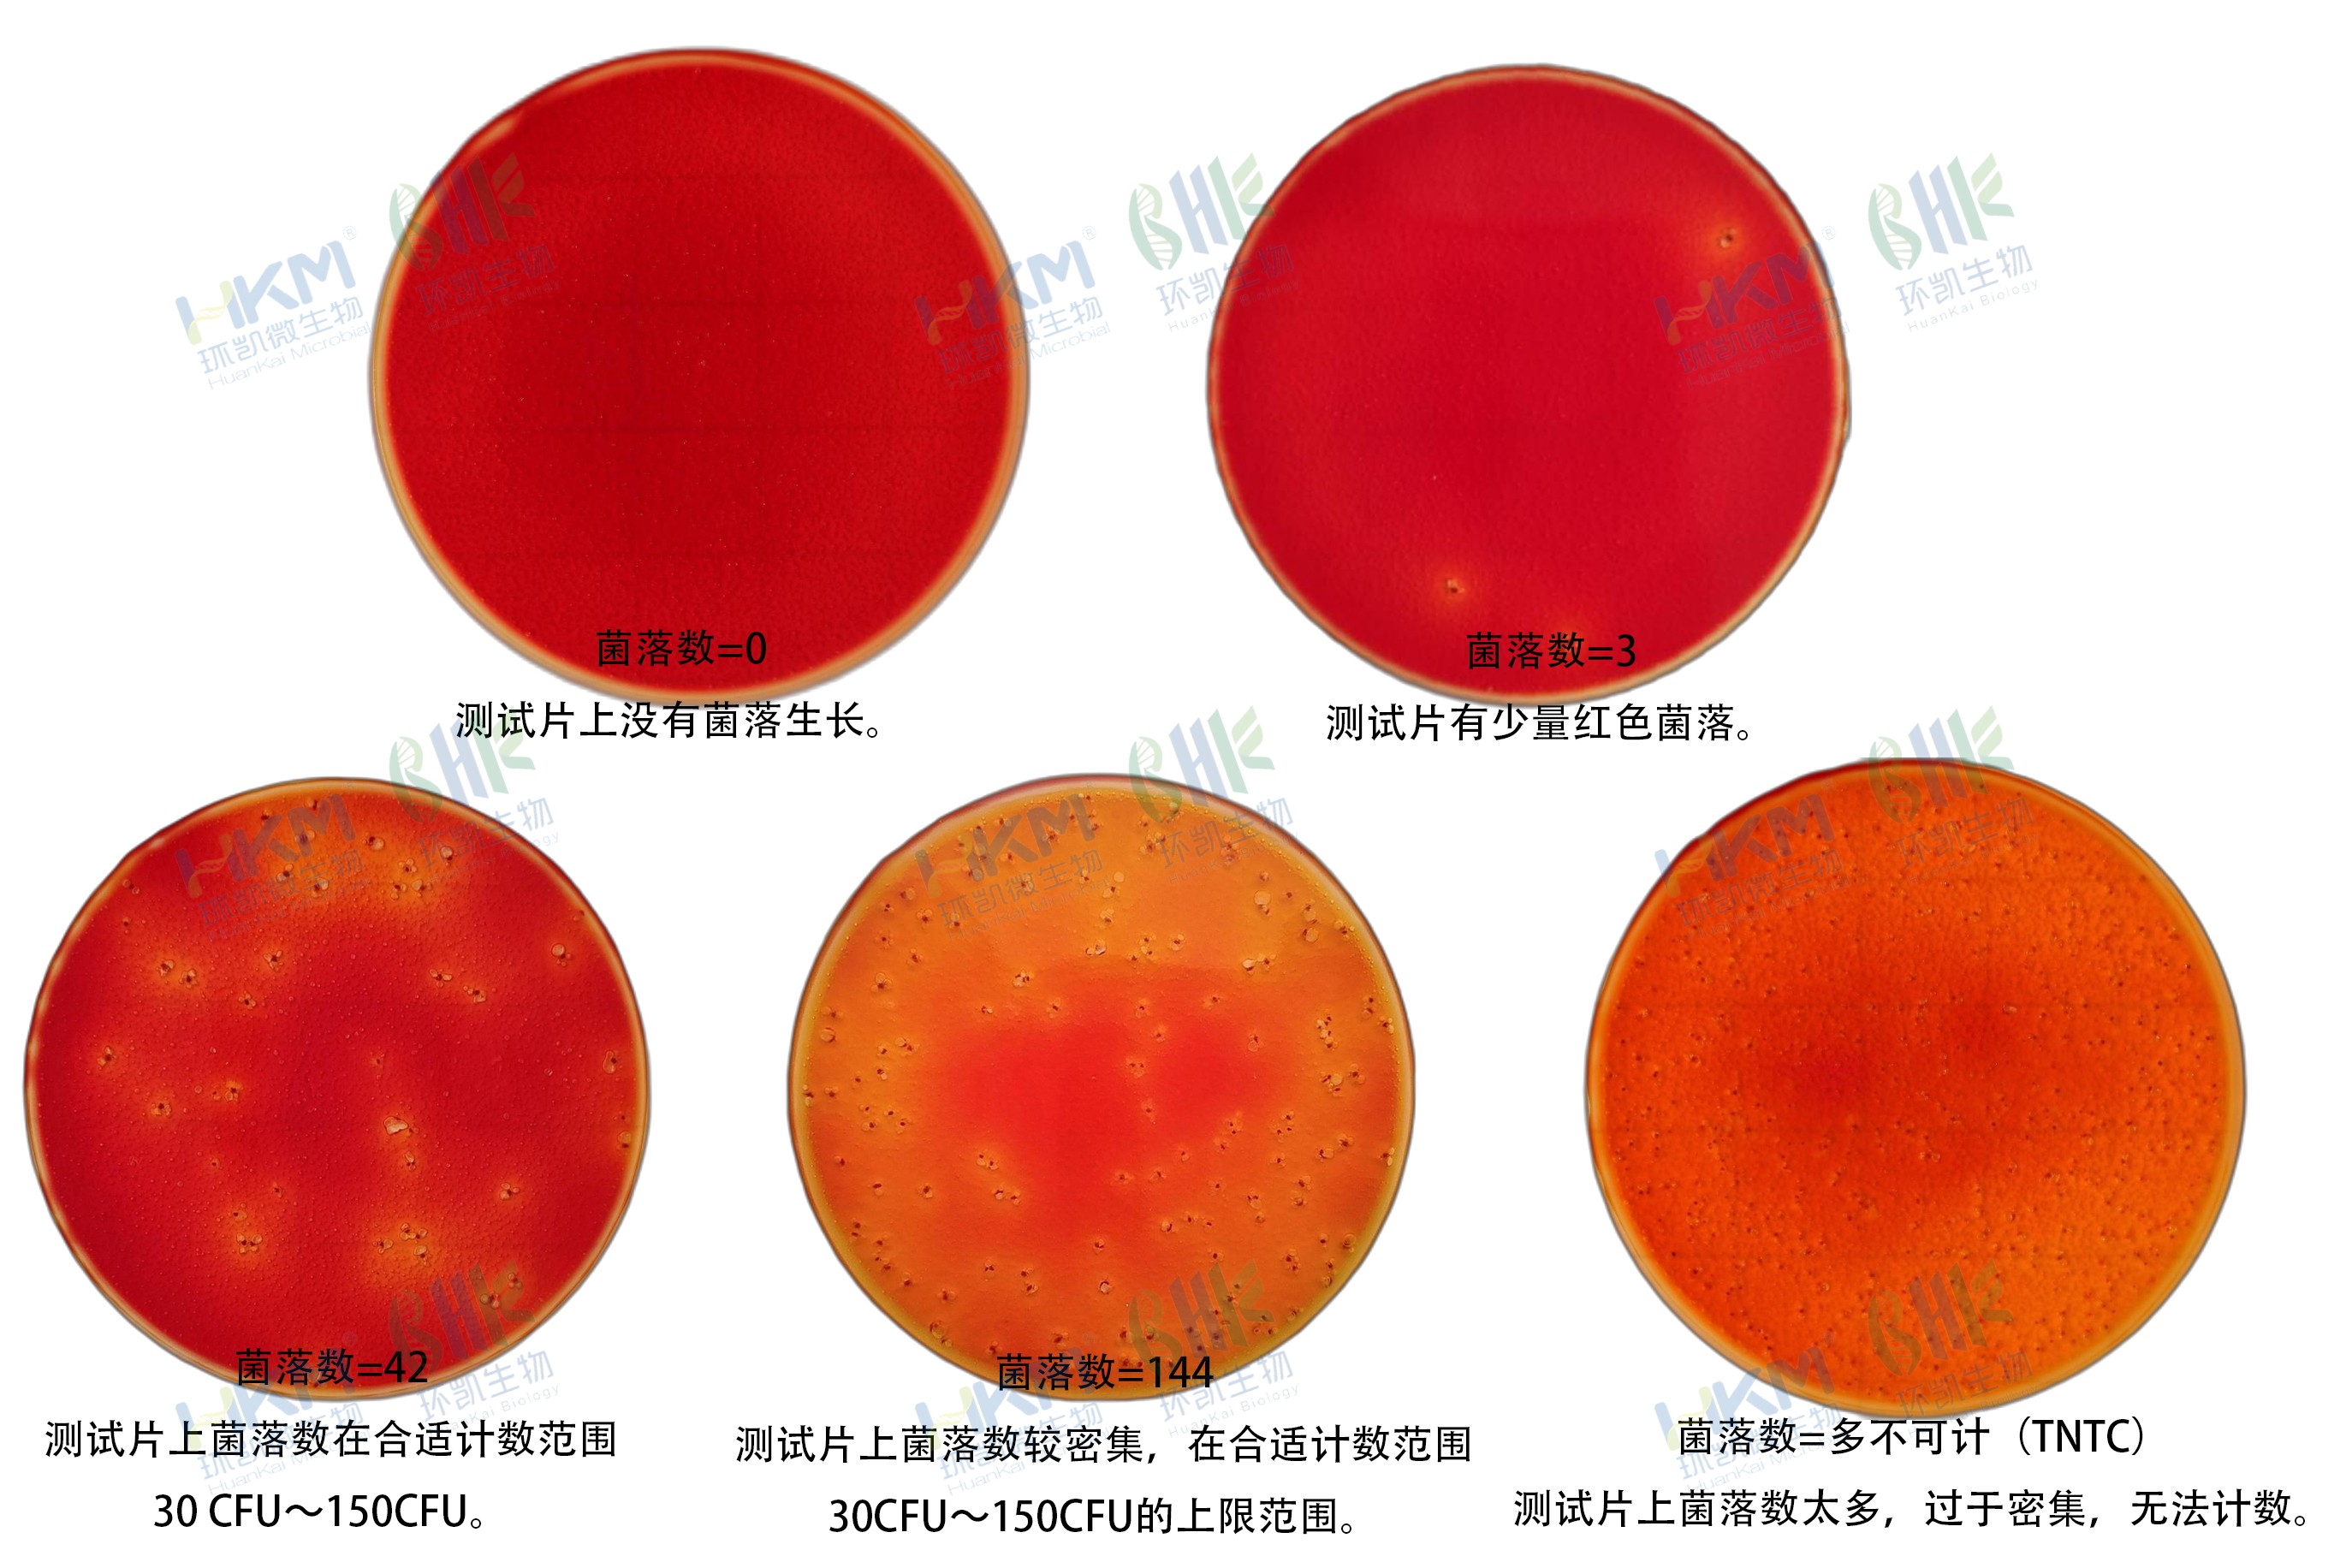
HandyPlate®大腸菌群測(cè)試片判讀手冊(cè) HandyPlate®大腸菌群測(cè)試片判讀手冊(cè)

產(chǎn)品名稱:大腸菌群測(cè)試片(GB4789.3-2025)
英文名稱:HandyPlate® Coliform Count Plate
產(chǎn)品編號(hào)與包裝規(guī)格:
| 產(chǎn)品編號(hào) | 產(chǎn)品類型 | 包裝規(guī)格 |
|---|---|---|
| HP002 | 微生物測(cè)試片 | 20片/袋 |
產(chǎn)品簡(jiǎn)介:Handy plate®大腸菌群測(cè)試片為預(yù)制備的即用型培養(yǎng)基產(chǎn)品,含有標(biāo)準(zhǔn)的培養(yǎng)基、冷水凝膠和顯色指示劑。本產(chǎn)品可用于食品和飲料中大腸菌群的測(cè)定(GB4789.3-2025)。
環(huán)凱 HandyPlate®大腸菌群測(cè)試片使用說(shuō)明:
1,樣品制備:取樣品 25 g(mL) 放入含有225 mL磷酸緩沖液(或生理鹽水)的無(wú)菌均質(zhì)杯或均質(zhì)袋內(nèi),均質(zhì)器混勻1 min~2 min 制成1:10的樣品勻液,必要時(shí)用無(wú)菌1 mol/L NaOH或1mol/L HCl溶液調(diào)節(jié)樣品勻液pH至6.8~7.2。用1mL無(wú)菌吸管或移液器吸取1:10勻液1 mL,注入含有9 mL稀釋液的試管內(nèi),振搖后成為1:100的樣品勻液,以此類推制備10倍系列稀釋的樣品勻液,每次換一支吸管或移液槍頭。
2,接種:根據(jù)對(duì)樣品污染狀況的估計(jì),選擇2~3個(gè)稀釋度進(jìn)行檢測(cè)。將大腸桿菌/大腸菌群測(cè)試片置于平坦實(shí)驗(yàn)臺(tái)面,揭開(kāi)上層膜,用無(wú)菌吸管或移液器吸取1 mL樣品勻液滴加到測(cè)試片中央,緩緩蓋上上層膜,排除多余空氣,邊緣少量氣泡不影響觀察結(jié)果。
3,培養(yǎng):將測(cè)試片正面向上水平放置到培養(yǎng)箱中,36℃±1℃條件下培養(yǎng)18h~24 h。
4,判讀:計(jì)數(shù)所有黃色酸環(huán),周圍有氣泡的紅色菌落。合適的計(jì)數(shù)范圍在15 CFU~150 CFU。如菌濃度過(guò)高,整個(gè)培養(yǎng)區(qū)域都呈黃色且無(wú)法計(jì)數(shù),需對(duì)樣品進(jìn)一步稀釋以獲得準(zhǔn)確的計(jì)數(shù)。如需分離菌落進(jìn)行進(jìn)一步分析,揭開(kāi)上層膜用接種針將菌落挑出即可。

儲(chǔ)存條件與保質(zhì)期:2~8℃密封儲(chǔ)存,有效期為18個(gè)月;已打開(kāi)包裝未使用的測(cè)試片裝回包裝袋中,折疊后用不干膠貼密封,儲(chǔ)存時(shí)間不超過(guò)4周為宜。
廢棄物處置:測(cè)試片在使用之后可能包含微生物,需在121℃ 30min高壓蒸汽滅菌處理后嚴(yán)格遵守按規(guī)定的方式處理。
環(huán)凱 HandyPlate®大腸菌群測(cè)試片 檢測(cè)結(jié)果可靠,經(jīng)驗(yàn)證與國(guó)家標(biāo)準(zhǔn)方法擬合度良好(右鍵“在新標(biāo)簽頁(yè)中打開(kāi)圖片”可查看高清大圖!)
| 純菌 | 樣品(人工污染和自然污染) |
|---|---|
![]() | ![]() |
環(huán)凱 HandyPlate®大腸菌群測(cè)試片判讀手冊(cè)(右鍵“在新標(biāo)簽頁(yè)中打開(kāi)圖片”可查看高清大圖?。?/span>
大腸菌群測(cè)試片為常溫常壓條件下制備的無(wú)菌的一次性產(chǎn)品,含有符合國(guó)家標(biāo)準(zhǔn)的培養(yǎng)基、耐液化的凝膠劑和TTC顯色指示劑。
按標(biāo)準(zhǔn)要求或說(shuō)明書(shū)推薦培養(yǎng)條件培養(yǎng)后,肉眼或借助放大鏡等計(jì)數(shù)所有紅色菌落。菌落數(shù)在30~150CFU之間較為適宜。按標(biāo)準(zhǔn)要求或說(shuō)明書(shū)推薦培養(yǎng)條件培養(yǎng)后,肉眼或借助放大鏡等計(jì)數(shù)所有紅色菌落。菌落數(shù)在30~150CFU之間較為適宜。按標(biāo)準(zhǔn)要求或說(shuō)明書(shū)推薦培養(yǎng)條件培養(yǎng)后,肉眼或借助放大鏡等計(jì)數(shù)所有紅色且周圍培養(yǎng)基變黃色,菌落周圍有氣泡的菌落。菌落數(shù)在30-150CFU之間較為適宜。紅色菌落周圍培養(yǎng)基變黃色,無(wú)氣泡的為其它雜菌。